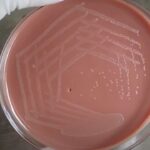
H. influenzae - Introduction, Morphology, Pathogenicity, Lab Diagnosis, Treatment, Prevention, and Keynotes

Tag: Chocolate agar
H. influenzae – Introduction, Morphology, Pathogenicity, Lab Diagnosis, Treatment, Prevention, and Keynotes
Introduction Haemophilus influenzae (often abbreviated as H. influenzae) is a...
Introduction Haemophilus influenzae (often abbreviated as H. influenzae) is a...
Culture media: Introduction, Composition, Types and Their Uses
 Introduction of culture media Media is plural while medium singular. Culture ...
Introduction of culture media Media is plural while medium singular. Culture ...
